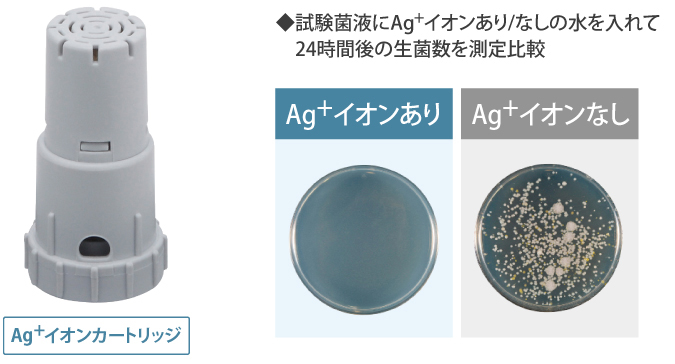
Máy sưởi gốm Sharp HX-RK12

THÔNG TIN SẢN PHẨM
Máy sưởi gốm Sharp HX-RK12 là dòng máy sưởi có tạo ẩm nội địa Nhật Bản. Máy được trang bị cảm biến nhiệt độ, độ ẩm cùng với công nghệ tạo ion Plasma độc quyền giúp bạn luôn thoải mái với không khí ấm áp.

Sau đây hãy cùng Hàng Nhật Bách Khoa tìm hiểu một vài tính năng nổi bật của máy sưởi gốm Sharp HX-RK12:
1.Thiết kế nhỏ gọn, tinh tế
Máy sưởi gốm Sharp HX-RK12 với thiết kế nhỏ gọn, hiện đại, được trang bị cảm biến nhiệt độ, độ ẩm cùng với công nghệ tạo ion Plasma độc quyền giúp bạn luôn thoải mái với không khí ấm áp. Nó có thể dễ dàng mang theo và sử dụng trong phòng khách, phòng ăn, phòng ngủ và phòng trẻ em.

2. Công nghệ sưởi gốm với khả năng làm nóng lượng lớn không khí
Khi sưởi ấm, máy sưởi gốm tạo ẩm Sharp HX-RK12 không đốt cháy oxy, không phát sáng, vận hành êm, tạo cảm giác dễ chịu và an toàn, đặc biệt khi sử dụng cho người già và trẻ nhỏ, không lo khô da hay viêm hô hấp.

Ngoài ra ở thế hệ mới này lượng không khí được hút vào đã được tăng lên gấp 2 bằng cách sử dụng một chiếc quạt có hình cánh bọ rùa, tạo ra gió mạnh và nhanh.

3. Khả năng bù ẩm thông minh và dưỡng ẩm cho da
Máy sưởi gốm Sharp HX-RK12 được trang bị bình nước bù ẩm lớn với dung tích lên đến 3,1 lít. Đây cũng là một trong những ưu điểm của máy, được trang bị các cảm biến siêu nhạy, máy sưởi gốm Sharp HX-RK12 có khả năng bù ẩm thông minh tùy theo độ ẩm của môi trường xung quanh. Nước được cung cấp từ đầu bộ lọc làm ẩm và được kiểm soát, bù ẩm cho không khí khô sau khi qua màng lọc.
Bộ phận tạo ẩm của máy với được nâng cấp với bộ tạo ion AG+ giúp ngăn chặn vi khuẩn trong nước đồng thời thấm vào nước trước khi đưa ra không khí giúp bảo vệ sức khỏe gia đình bạn.
4. Công nghệ Ion Plasma
Sử dụng công nghệ tạo ion Plasma với mật độ 7000/cm³ , máy sưởi gốm tạo ẩm Sharp HX-RK12 khử mùi hiệu quả các mùi: thuốc lá, mùi ẩm mốc, thức ăn, vật nuôi…

5. Tự động làm sạch bộ tạo ẩm
Sau khi máy ngừng hoạt động, bộ lọc tạo ẩm sẽ tự động được làm sạch, giúp ngăn chặn sự phát triển của vi khuẩn, nấm mốc


6. Tính năng an toàn
Chế độ bảo vệ quá nhiệt và tự ngắt khi đổ ngã, chế độ hẹn giờ đáp ứng tối đa nhu cầu sử dụng của mọi lứa tuổi. Ngoài ra, trong quá trình hoạt động, nó sẽ tự động tắt nếu không hoạt động trong 8 giờ.







đánh giá nào
Chưa có đánh giá nào.